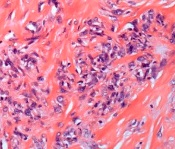

骨肿瘤
低级别中心型骨肉瘤的研究进展
学术进展
2025-12-16
发现导致多发性良性软骨肿瘤的酶
学术进展
2025-12-09

骨巨细胞瘤的影像学特征与鉴别诊断
学术进展
2025-10-11

开展骨肿瘤治疗的技术探索,提高临床治疗水平
学术进展
2025-07-26
脊柱骨母细胞瘤继发动脉瘤样骨囊肿:1例
病例
2025-07-03

未分化多形性肉瘤患者的个体化全股骨与膝关节人工假体置换一例
病例
2025-06-18

胫骨近端实性动脉瘤样骨囊肿1例
病例
2025-03-26

青少年股骨头软骨母细胞瘤1例
病例
2024-10-20

骨盆及骶骨肿瘤切除术中腹主动脉球囊临时阻断技术专家共识(2025年版)
指南
2025-10-12
中国腱鞘巨细胞瘤临床诊疗专家共识
指南
2025-10-02
177Lu-DOTA-IBA治疗肿瘤骨转移的临床实践指南 (2025年版)
指南
2025-06-24
2024 ACR适宜性标准:疑似原发性骨肿瘤(更新版)
指南
2025-06-19
注射用氨磷汀
本品为正常细胞保护剂,主要用于各种癌症的辅助治疗。在对肺癌、卵巢癌、乳腺癌、鼻咽癌、骨肿瘤、消化道肿
注射用氨磷汀
本品为正常细胞保护剂,主要用于各种癌症的辅助治疗。在对肺癌、卵巢癌、乳腺癌、鼻咽癌、骨肿瘤、消化道肿
锝[99mTc]亚甲基二膦酸盐注射液
主要用于全身或局部骨显像,诊断骨关节疾病、原发或转移性骨肿瘤病等。